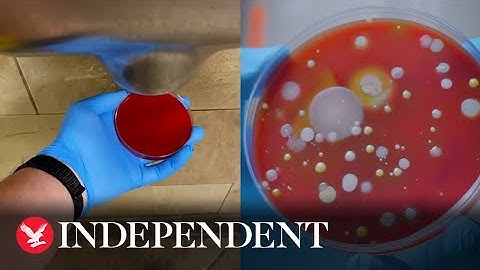
Experiment shows disgusting bacteria harboured by hand dryers

⬇ DOWNLOAD NOW
Kalau muncul iklan pop-up, tutup lalu klik tombol kembali
Download lagu Hand Dryer Using Arduino secara gratis hanya untuk keperluan promosi. Dukung artis favorit kamu dengan membeli musik original di iTunes atau platform resmi lainnya.
 How to make an Automatic Hand Dryer (Arduino Project)
How to make an Automatic Hand Dryer (Arduino Project)
 How germy are hand air dryers…again?
How germy are hand air dryers…again?
 ARDUINO PROJECT HAND DRYER
ARDUINO PROJECT HAND DRYER
 Final Project - Hand Dryer
Final Project - Hand Dryer
 Commercial Automatic Hand Dryer with Drain Tank ABS Cover Wall Mounted Fast Drying
Commercial Automatic Hand Dryer with Drain Tank ABS Cover Wall Mounted Fast Drying
 hand dryer using relay module , ir sensor and battery
hand dryer using relay module , ir sensor and battery
Experiment shows disgusting bacteria harboured by hand dryers
Experiment shows disgusting bacteria harboured by hand dryers
 Hand Dryer PLTW CIM
Hand Dryer PLTW CIM